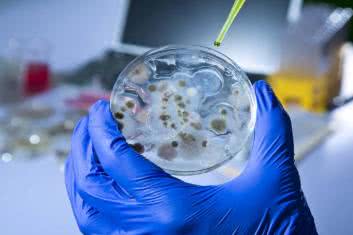
Jeśli nie antybiotyk, to co?

- Agent AI
- Problemy zdrowotne
- ADHD
- Alergie
- Astma
- Autyzm
- Bezsenność
- Borelioza
- Bóle głowy i migreny
- Celiakia
- Choroba Alzheimera
- Choroba Parkinsona
- Choroby jelit
- Choroby kobiece
- Choroby laryngologiczne
- Choroby oczu i wady wzroku
- Choroby rzadkie
- Choroby serca
- Choroby skóry
- Choroby tarczycy
- Choroby układu moczowo-płciowego
- Choroby układu oddechowego
- Choroby układu krążenia
- Choroby układu pokarmowego
- Choroby wątroby
- Choroby zakaźne i pasożytnicze
- Choroby zębów i dziąseł
- Chroniczne zmęczenie
- Cukrzyca
- Depresja
- Grypa i przeziębienie
- Insulinooporność
- Kości, mięśnie, stawy
- Krew
- Menopauza
- Nadciśnienie tętnicze
- Nadwaga i otyłość
- Niepłodność
- Nowotwory
- Odporność
- Osteoporoza
- Pęcherz i nerki
- Stwardnienie rozsiane (SM)
- Udar mózgu
- Uzależnienia
- Wysoki cholesterol
- Zaburzenia hormonalne
- Zaburzenia odżywiania
- Zaburzenia pamięci i koncentracji
- Zaburzenia psychiczne i choroby układu nerwowego
- Zaburzenie mikrobioty jelitowej
- Choroby od A do Z
- Leczenie
- Odżywianie
- Terapie naturalne
- Zioła i superfoods
- Zagrożenia dla zdrowia
- Styl życia
- Raporty
Szukaj
 Nasze magazyny
Nasze magazyny






 Spis treści
Spis treści

Archiwum wszystkich numerów
Archiwum wszystkich numerów














